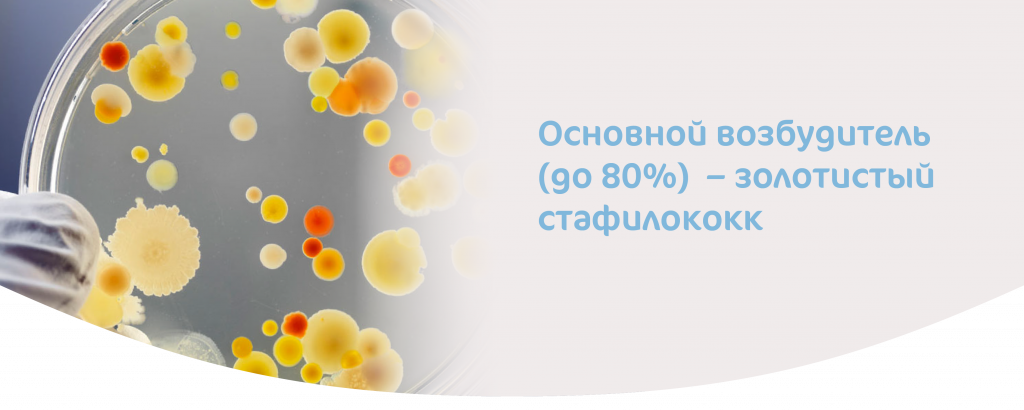
МАСТИТ_У МАТЕРЕЙ-02.png

Мастит: причины, симптомы, лечение
Статья носит исключительно справочный характер. Поставить точный диагноз и назначить индивидуальное лечение может только доктор.
Мастит при грудном вскармливании – воспаление грудных желез бактериального характера, возникающее после родов и связанное с грудным вскармливанием. Заболевание может возникать в больничных условиях, однако современная статистика говорит о том, что в современном мире мастит чаще всего развивается уже в домашних условиях, на 2-4 неделе после родов. В 90% случаев поражается одна грудная железа, но встречается и двусторонний мастит.
Основной возбудитель (до 80%) – золотистый стафилококк, но встречаются и другие возбудители (Streptococcus A и B, Enterobacter spp., Escherichia spp., Pseudomonas aerugenosa, Klebsiella spp.)
Виды мастита
На самом деле течение мастита различается скорее не по видам, а по стадиям или характеру воспаления, которые могут принять следующие формы
- патологический лактостаз;
- серозный мастит;
- инфильтративный мастит;
- гнойный мастит

Симптомы мастита
Патологический мастит обычно возникает в течение недели лактации, сопровождается равномерным нагрубанием и болезненностью молочных желез, часто повышением температуры до 38–38,5 С.
Серозный мастит обычно проходит уже в более острой форме. Наблюдаются озноб и слабость, температура может повышаться до 39С, грудь может увеличиться в объеме, уплотнения умеренно-болезненные, усиливается боль, особенно при кормлении ребенка. При отсутствии лечения серозный мастит может в течение 1-3 дней перейти с инфильтративный.
Инфильтративный мастит – как правило в эту форму переходит серозная форма при запоздалом или неправильном лечении. Переход происходит быстро – в течение 1-3 дней. Уплотнения становятся плотными и неподатливыми, могут воспалиться подмышечные лимфатические узлы. Лихорадка не проходит. Эта стадия чаще длится от 5 до 10 дней, а иногда и гораздо быстрее (4-5 дней). Если инфильтрат не рассасывается, то мастит переходит с следующую фазу – гнойную.
Гнойный мастит. Сохраняется высокая температура (до 40С) и озноб, часто пропадает аппетит, происходит покраснение кожи груди, усиливается болезненность, подмышечные узлы болезненны. Гнойный мастит может принимать различные формы - нфильтративно-гнойный (диффузный, узловой), абсцедирующий (фурункул ареолы, абсцесс в толще железы, ретромамарный абсцесс), флегмонозный (гнойно-некротический), гангренозный.
Мастит и лактостаз.
Очень важно отличатьлактостаз от мастита. Лактостаз – повышенное образование грудного молока при его недостаточном оттоке не носит бактериальный характер и требует коррекции, которая помогает избежать мастита, как возможного следствия лактостаза. В настоящее времяспециалисты часто рассматривают лактостаз как неинфекционный мастит. При отсутствии лечения лактостаза он может перейти и в инфекционный мастит, когда инфекция попадает в организм через трещины на сосках.
О том как справиться с лактостазом, читайте – ссылка (статья КОЧЕВОЙ)
Причины
Чаще всего возникновению мастита способствуют следующие факторы:
- лактостаз (застой молока в одной или обеих грудных железах)
- трещины сосков
- аномалии развития сосков (плоские, втянутые, добавочные)
- структурные изменения молочных желез (мастопатия, добавочные доли, большие размеры молочных желез, рубцовые изменения)
- гнойный мастит в анамнезе
- снижение иммунной реактивности организма
- пластика молочных желез
- гипер- и гипогалактия (чрезмерная или недостаточная лактация)
- нарушение гигиены и правил грудного вскармливания
Диагностика
Поздняя диагностика, неправильное лечение, быстрое развитие воспалительных процессов при неочевидности внешней симптоматики могут затруднить лечение болезни.

Для более точной диагностики состояния обычно применяются следующие методы исследования:
- Клинический анализ крови: лейкоцитоз, сдвиг лейкоцитарной формулы влево, нарастание СОЭ.
- Бактериологическое исследование молока с количественной оценкой обсемененности молока (>5х102 КОЕ/мл), определение чувствительности к антибиотикам. Исследование желательно проводить до начала антибиотикотерапии. Молоко для исследования берут из пораженной и здоровой молочной желез.
- Ультразвуковое исследование.
Внимание! Прокомментировать результаты исследований может только опытный доктор, который и назначит обследование и лечение. Народные методы и самолечение могут привести к серьезным осложнениям.
Лечение
Комплексное лечение мастита состоит в подавлении возбудителя, купировании симптомов, профилактике осложнений. Лекарственные средства (антибактериальная, антигрибковая терапия и пр.) обязательны и их назначает только доктор. Кроме того, в лечении часто применяется физиотерапия. При некоторых формах мастита возможно потребуется медикаментозное подавление лактации при помощи специальных препаратов, назначаемых доктором с согласия кормящей матери. При гнойном мастите требуется хирургическое вмешательство.
Критериями успешного лечения являются:
- улучшение состояния заболевшей
- нормализация температуры тела, показателей крови
- бактериологическая стерильность молока и раневого отделяемого
- предотвращение развития гнойного процесса в молочной железе при серозном и инфильтративном мастите
- заживление ран после оперативных вмешательств
- отсутствие рецидивов гнойного мастита
Профилактика
Профилактика мастита включает:
- строгая гигиена – личная, медицинского учреждения и дома
- правильный уход за грудной железой и сосками
- правильное и своевременное сцеживание
- правильное прикладывание к груди
- профилактика лактостаза с использованием молокоотсосов в послеродовой период
Мастит и грудное вскармливание
Иногда при серозном и инфильтративном мастите требуется временное подавление грудного вскармливания.При гнойном мастите грудное вскармливание прекращается в обязательном порядке. Решение о подавлении или прекращении грудного вскармливания принимает доктор с ведома и по согласованию с кормящей матерью. В этом случае на помощь приходят молочные смеси.

По вопросу выбора смеси проконсультируйтесь с педиатром. Подумайте и о том, какую смесь лучше выбрать – на козьем или коровьем молоке. Клинически доказано, что козье молоко и продукты на его основе, например, смеси Кабрита для здоровых детей с рождения усваиваются быстрее и легче коровьего. Это значит, что ребенок не только получит, но и усвоит максимум питательных веществ для своего роста, развития и защиты.
Читай также
Витамин D для детей, давать или нет?
Недобор веса у грудничка
Ребенок срыгивает после кормления